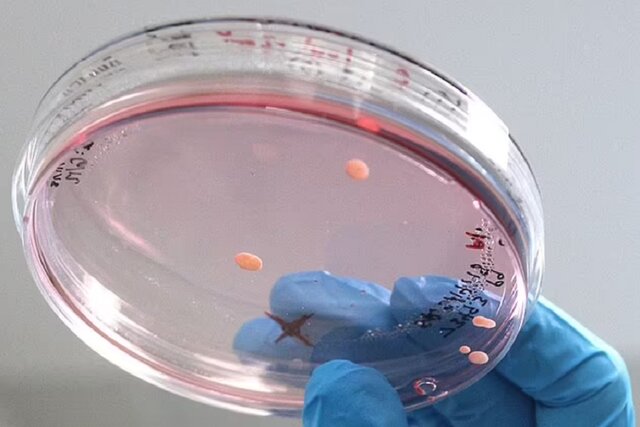

به گزارش ایسنا و به نقل از دیلی میل، ارگانوئیدهای مشابه مغز که از سلولهای یک فرد مبتلا به اوتیسم پرورش یافتهاند، نشان میدهند که نورونهای بیشفعال در مغز ممکن است به این اختلال کمک کنند.
ارگانوئیدها، تودههایی از سلولهایی هستند که به طور مصنوعی رشد کردهاند و شبیه به یک اندام هستند. ارگانوئیدهایی که در یک پژوهش جدید برای شبیهسازی قشر مغز ایجاد شدهاند، به دانشمندان "دانشگاه یوتا" (UofU) امکان دادهاند تا این بخش از مغز را که مانند یک راز باقی مانده است، از نزدیک بررسی کنند.
این مغزهای کوچک، در آزمایشگاه با استفاده از سلولهای بنیادی یک فرد مبتلا به اوتیسم پرورش داده شدند و به دانشمندان امکان دادند تا ببینند که نورونها چگونه ممکن است در افراد مبتلا به این اختلال متفاوت باشند.
"یوکی وانگ" (Yueqi Wang)، پژوهشگر ارشد این پروژه گفت: استفاده از این ارگانوئیدها میتواند به دانشمندان کمک کند تا ببینند که در مراحل اولیه بیماریهای عصبی و پیش از بروز علائم، چه اتفاقی رخ میدهد.
پژوهشگران برای ایجاد ارگانوئیدها، به بررسی چگونگی رشد طبیعی مغز پرداختند و سلولهای بنیادی انسان را وادار کردند تا همان مسیر را دنبال کنند. سلولهای بنیادی کار خود را به عنوان سلولهای عصبی اپیتلیال آغاز کردند. این سلولها، یک نوع سلول بنیادی خاص هستند که ساختارهای خودسازماندهیشدهای به نام "روزتهای عصبی" (neural rosettes) را در ظرف آزمایشگاهی تشکیل میدهند. سپس، سلولها رها شدند تا خودبهخود رشد کنند. ساختارها طی چند ماه، به کُرههایی تبدیل شدند و اندازه و پیچیدگی آنها با همان سرعتی که مغز در جنین رشد میکند، افزایش یافت.
"الکس شچگلوویتوف" (Alex Shcheglovitov)، دانشیار علوم اعصاب دانشگاه یوتا گفت: گروه ما پس از پنج ماه دریافتند که این ارگانوئیدها شبیه به نوعی از چین و چروک در مغز جنین هستند.
این ساختارها شامل مجموعهای از انواع سلولهای عصبی و سایر سلولهای موجود در قشر مغز هستند که بیرونیترین لایه مغز است و در زبان، احساسات، استدلال و سایر فرآیندهای ذهنی نقش دارد.
وانگ گفت: ما در حال درک چگونگی ساختارهای عصبی پیچیده در مغز انسان هستیم و میتوانیم فنوتیپهای مرتبط با بیماری را با استفاده از ارگانوئیدهای سهبعدی بررسی کنیم که از سلولهای بنیادی حاوی جهشهای ژنتیکی به دست آمدهاند.
در هر حال، بحثهایی در مورد مینیمغزهای پرورشیافته در آزمایشگاه وجود دارد زیرا برخی از پژوهشگران نگران هستند که این ارگانوئیدها در نهایت برای درک بهتر اختلالات عصبی، در حیوانات کاشته شوند.
این هشدار از سوی گروهی از پژوهشگران "دانشگاه کیوتو" (Kyoto University) مطرح شد که مقالهای را در سال ۲۰۲۱ منتشر کردند و در آن، به ذکر تعدادی از پیامدهای اخلاقی پرداختند که ممکن است در تحقیقات ارگانوئید مغز به وجود بیایند.
"تسوتومو ساوای" (Tsutomu Sawai)، دانشیار دانشگاه کیوتو گفت: این موضوع خیلی آیندهنگرانه است اما این بدان معنا نیست که ما باید منتظر تصمیمگیری درباره دستورالعملهای اخلاقی باشیم.
ارگانوئیدهای مغز که نخستین بار در سال ۲۰۰۸ ساخته شدند، کُرههای سهبعدی از بافت شبیه به مغز هستند که از سلولهای بنیادی و معمولا از سلولهای انسان پرورش مییابند.
سایر پژوهشهای شامل سلولهای بنیادی، استفاده از بافت حیوانی را برای پرورش ارگانوئیدها در بر میگیرند که به حیوانات دیگر پیوند زده میشوند. به عنوان مثال، دانشمندان با موفقیت پانکراس یک موش معمولی را در بدن موش صحرایی پرورش دادند.
این کار پیشگامانه، راه را برای پرورش پانکراس انسان در خوکها هموار میکند که بعدا میتوان از آنها برای پیوند اعضای بدن استفاده کرد. با وجود این، ساوای گفت که موضوع مهمتری نیز وجود دارد. وی خاطرنشان کرد: یکی از بزرگترین مشکلات، پیوند است. آیا باید ارگانوئیدهای مغزی را در حیوانات قرار دهیم تا نحوه رفتار مغز را مشاهده کنیم؟
ساوای هشدار داد که انجام دادن این کار میتواند به افزایش تواناییهای حیوانات منجر شود که ممکن است درست شبیه به ماجرای فیلم "سیاره میمونها" (Planet of the Apes) باشد.
داستان سیاره میمونها، در آینده و در سیارهای دور اتفاق میافتد. سه فضانورد در این سیاره سرگردان میشوند و میفهمند که جهان توسط میمونهای هوشمند اداره میشود.
اگرچه پرورش کل مغز انسان در بدن حیوانات مورد توجه جدی نیست اما پیوند ارگانوئیدهای مغزی میتواند بینش مهمی را در مورد چگونگی شکلگیری بیماریهایی مانند زوال عقل یا اسکیزوفرنی و درمانهایی برای آنها ارائه دهد.
ارگانوئیدهای مغزی، روش جدیدی را برای مطالعه مغز انسان، درک بهتر نحوه رشد آن و یادگیری در مورد چگونگی پیشروی بیماریها در اختیار دانشمندان قرار دادهاند.
انتهای پیام